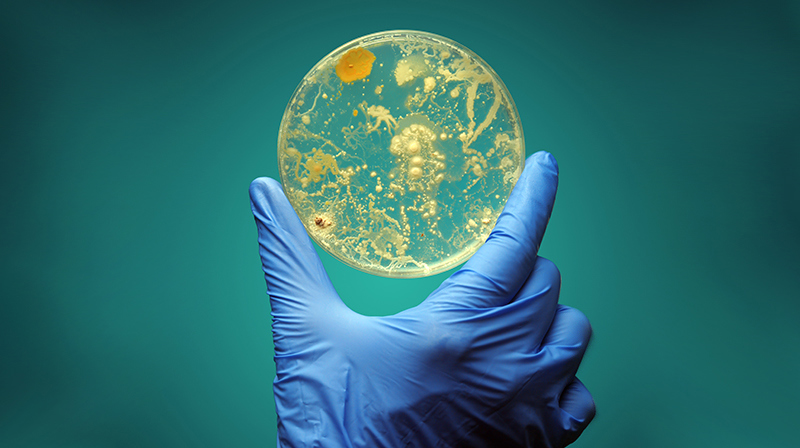

Get Involved
Take on a challenge, buy our pin badge to raise awareness or add your voice to our campaigns. Together, we can create a world where no man dies of prostate cancer. Join our mailing list for more ways to get involved.

Campaigning for change
We want men with prostate cancer to get an earlier diagnosis, better treatment and better support. We’re pushing for change. But we can’t do it alone: we need your help.
Add your voice


Organise your own fundraising
Organising your own fundraising, or want to? We've got you covered for ideas, materials, advice and help.
Find out more

Volunteering and Involvement
Volunteer your time and help us raise funds and awareness to improve the lives of men with Prostate Cancer.
Find out more

Shop
Kitting yourself out or looking for a special gift? We've got you covered in our online shop.
Find out more

Corporate Partnerships
Your organisation and ours could make the perfect team. Here's what we have to offer.
Charity partnerships

Prostate Cancer Memorial
The Prostate Cancer Memorial is a remembrance sculpture dedicated to the husbands, dads, uncles and grandads who’ve been lost to prostate cancer.
Find out more

Share your story
We are always looking for people affected by prostate cancer to support us with our vital work and help raise awareness of the disease.
Find out more
Activities




Cycling
Explore in-person cycle rides, challenges you can do in your own time, or organise your own ride.
Find out more